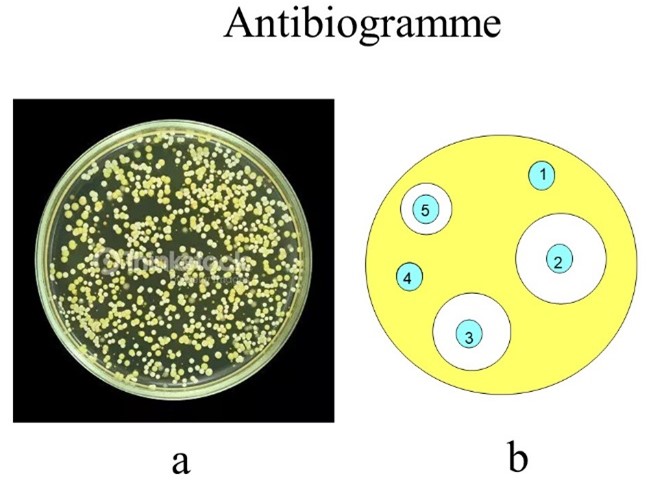

Zoom sur la résistance des bactéries aux antibactériens
L'objectif de la bactérie [1], qui est un procaryote donc dépourvue de noyau (fig. 1), est de se multiplier et « d'occuper le terrain ». C'est d'ailleurs pourquoi de nombreux antibactériens sont produits par des microorganismes, qui éliminent ainsi les concurrents pour être les seuls à disposer des ressources nutritives [2].

Figure 1
Comme on va le voir, les bactéries savent, depuis toujours, trouver des parades à tout ce qui peut perturber leur développement [3], et en particulier la présence d'agents antimicrobiens.
Elles peuvent devenir Résistantes (R) : la résistance aux antibactériens étant définie comme la capacité d'une bactérie à se multiplier en présence d'une concentration d'antibiotique supérieure à celle que l'on peut obtenir in vivo(i). Cela peut conduire à un échec thérapeutique.
Comment déterminer si une bactérie est sensible ou résistante ?
En cas d'infection persistante malgré un traitement approprié, ou dans les cas graves, le médecin fait un prélèvement(ii) et demande au laboratoire de réaliser un antibiogramme. Le principe est de cultiver la bactérie en présence de divers antibactériens et de voir si elle « pousse » ou si sa croissance est inhibée.
Il existe diverses méthodes plus ou moins automatisées, mais la plus simple à comprendre est d'opérer en boite de Pétri(iii). Sur un milieu nutritif et solide placé à 37°C pendant 15 à 24h les bactéries se développent (fig. 2a). Si avant de mettre à l'étuve on pose sur la boîte des disques de papier imprégnés de quantités standardisées de chaque antibactérien à tester, le diamètre d'inhibition de pousse autour de chaque disque indique le niveau de sensibilité de la souche à l'antibactérien : un contact indique que la résistance est élevée (fig. 2b). Ainsi, la bactérie représentée en jaune est très résistante (R) aux produits 1 et 4, résistante à 5 et sensible (S) à 2 et 3. On appelle Concentration Minimale Inhibitrice ou CMI la concentration d'antibactérien la plus faible pour laquelle il n'y a pas de croissance visible. Cette expérience est une expérience in vitro (fig. 3).
Figures 2a et 2b

Figure 3
Résistance naturelle
C'est une propriété commune à toutes les bactéries d'une même espèce, due le plus souvent à la nature des enveloppes de la bactérie (fig. 4). Chez les bactéries Gram -, le peptidoglycane est entouré d'une membrane externe asymétrique, dont la partie extérieure, le lipopolysaccharide(iv), empêche la pénétration des molécules hydrophobes à cause de la chaîne de sucres, et celle des hydrophiles à cause de la partie lipidique. Ce n'est que par des canaux emplis d'eau, les porines, que les antibactériens hydrophiles peuvent entrer. Certaines bactéries ont des porines très étroites – c'est le cas des mycobactéries – qui restreignent encore le passage, d’où une résistance importante.

Figure 4
Résistance aux antibactériens
La chimie des médicaments [4] et l’usage des antibactériens a révolutionné la mortalité par infection et à la fin des années 1960, le problème des infections bactériennes semblait résolu. Mais l’évolution naturelle des bactéries dans un environnement contenant des antibactériens les a conduites à développer des mécanismes de résistance, processus accru par l’usage inconsidéré des agents antibactériens. C’est un problème général auquel la France est bien loin d'échapper [5]. Chaque année en Europe, l'antibiorésistance provoque 30.000 morts, et la morbidité est aussi importante que celle de la grippe, de la tuberculose et du VIH/SIDA combinés. À côté du problème de la résistance proprement dite, les conséquences de l'usage accru des antibiotiques sont la multirésistance (une bactérie devient résistante à plusieurs antibactériens de familles différentes), la contamination de l'environnement par les antibactériens et leurs métabolites(v), qui finiront par être ingérés par les humains et les animaux, contaminant encore plus l'environnement. Concernant les antibiotiques donnés aux animaux soit pour raison prophylactique, soit comme stimulant de la croissance, cet usage est interdit en Europe, mais toujours existant aux États-Unis.
Les voyages plus fréquents, les rassemblements, facilitent la dispersion des germes résistants, par simple contact, hors infection. Enfin, les progrès de la médecine ont accru le nombre de personnes fragiles : personnes âgées, immunodéprimées (greffées), pathologies chroniques, porteurs de prothèses... Même la tuberculose, qui semblait éradiquée en France, s'y rencontre à nouveau.
N'oublions pas que la plupart des antibactériens sont d'origine microbienne, ce qui facilite la mise en œuvre de mécanismes de résistance préexistant(vi).
Mécanismes moléculaires de la résistance
Les principaux mécanismes sont schématisés figure 5 :
- empêcher la pénétration de l’antibactérien : modification des porines (Gram -) de la membrane externe
- éjecter l’antibactérien : pompes d’efflux (fig. 6) dans la membrane interne
- modification de l’antibactérien, qui ne sera plus actif : enzymes d’inactivation (fig. 7 pour la pénicilline)
- modification de la cible :
- plus grande quantité de cible, rendant la quantité d'antibactérien insuffisante,
- mutation de la cible, qui ne sera plus reconnue et fonctionnera à nouveau normalement.
![]() | ![]() |

Figure 7
Bases génétiques de la résistance
Toute propriété est codée au niveau de l'ADN. Si le phénomène conduisant à la résistance est porté par le chromosome seuls les bactéries filles sont résistantes(vii).
Mais il existe des éléments mobiles, c'est à dire des fragments d'ADN autres que le chromosome, les plasmides par exemple (fig. 8), qui, s'ils codent pour la résistance, peuvent permettre sa dissémination rapide entre diverses bactéries. La figure10 montre que le plasmide d'une bactérie résistante « bleue » peut se dupliquer, puis une copie est transférée par contact avec une bactérie sensible « jaune », qui deviendra alors résistante.

Figure 8
.png)
Figure 9
En conclusion, on voit que le problème de la lutte contre les infections est loin d'être résolu, qu'il faut que patients et prescripteurs sachent être raisonnables en respectant la consigne de la campagne d’information « les antibiotiques, c’est pas automatique », [6] et que l'industrie pharmaceutique ne néglige plus la recherche en antibiothérapie [4] [5].

(i) In vivo : sur un animal vivant ; in vitro : dans un tube à essais; ex vivo : sur un organe ou une cellule isolée.
(ii) Gorge, prélèvement d'urine, de crachat ou intervention plus invasive.
(iii) Du nom du bactériologiste allemand Julius Richard Petri (1852–1921), qui était l'assistant du docteur Robert Koch (découvreur du bacille de la tuberculose) et grand rival de Louis Pasteur : voir le livre « Peste et Choléra » de Patrick Deville.
(iv) Le mot lipopolysaccharide est composé de « lipo » : lipide et "saccharide": sucre.
(v) Quand on donne un médicament à un être vivant, son organisme le transforme (on dit « le métabolise ») en une molécule capable d'être éliminée, appelée métabolite.
(vi) Le producteur d'antibiotique ne doit pas être détruit par les molécules qu'il fabrique !
(vii) Ces bactéries filles coexistent au sein d’une population où il y a d'autres bactéries de même espèce, mais qui n'ont pas développé de résistance.
Pour en savoir plus
[1] Parasite, champignon, bactérie et virus : quelles différences ?, N. J. Moreau, Question du mois, Mediachimie.org (2020)
[2] Zoom sur les bactéries et antibactériens, N. J. Moreau, Zoom sur..., Mediachimie.org (2023)
[3] On regardera avec intérêt Bactéries, nos amies ? CERIMES (1 janvier 1990) Canal-u.tv
[4]Chimie et médicaments : un bel avenir !, B. Meunier, Colloque chimie et nouvelles thérapies (novembre 2019)
[5] Comment vaincre la résistance aux maladies infectieuses ?,B. Meunier, V. Jarlier et Ph. Guérin - article en partenariat Académie des sciences et le Figaro (mai 2013)
[6] Les antibiotiques : des médicaments essentiels à préserver, sur le site de la MGEN (novembre 2022)
Crédits :
- illustration : Image par OpenClipart-Vectors de Pixabay
- figures : © NJ Moreau

